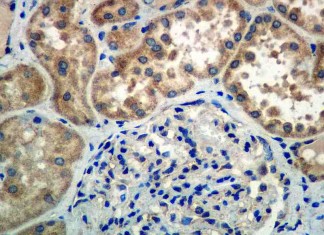

Cientificos descubren sistema de limpieza del cerebro hasta ahora desconocido
Un sistema no reconocido previamente que drena los desechos desde el cerebro a un ritmo muy rápido ha sido descubierto por neurocientíficos de la...
EE.UU. advierte sobre el uso de la codeína en niños
La FDA advirtió a los médicos y cuidadores el miércoles pasado sobre los riesgos de dar codeína para aliviar el dolor a los niños...
Las píldoras anticonceptivas ofrecen a las mujeres alivio del dolor
Tomar anticonceptivos orales de forma continua, en lugar de como tradicionalmente se prescribe para cada ciclo, proporciona alivio en los dolores menstruales - dismenorrea...
Investigadores identifican bacterias intestinales relacionados con la obesidad y el síndrome...
Investigadores de la Facultad de la Universidad de Maryland han identificado 26 especies de bacterias en la flora intestinal humana que parecen estar relacionados...
Un estudio halla que las mujeres tienen altas tasas de apnea...
Una nueva investigación ha encontrado altos índices de apnea del sueño en las mujeres, a pesar de la condición por lo general se considera...
La estimulación cerebral profunda para el tratamiento del síndrome de Tourette
Diez de los 11 pacientes con síndrome de Tourette severa han reportado mejoría después de recibir la terapia de estimulación cerebral profunda, de acuerdo...
La inflamación conduce la enfermedad de Crohn
La inflamación - no la susceptibilidad genética - impulsa el crecimiento de las bacterias intestinales y la invasión de E. coli relacionados con la...
Científicos descubren estrategia capaz de reducir efectos secundarios de la quimioterapia
Los investigadores de Leuven (VIB / KU Leuven) han confirmado su hipótesis de que la normalización de los vasos sanguíneos por PHD2 con un...
Descubierto el misterio de lo que hace los espermatozoides nadar
El gen no estaba en la lista de los fantasmas que juegan cuando Woody Allen escribió en su película El ABC del Amor de...
Investigadores descubren una nueva terapia que previene el crecimiento de cáncer...
El cáncer de pulmón es uno de los tipos más agresivos de cáncer y la causa más común de muerte por esta enfermedad en...
¿Por qué la gente tiene con tanta frecuencia un exceso de...
Los investigadores han sabido por mucho tiempo que la gente tiene a menudo exceso de confianza - que tienden a creer que son físicamente...
Proteómica urinaria ayuda a la identificación precoz de la nefropatía diabética
Un clasificador de biomarcadores en la orina puede permitir la detección precoz de la progresión a nefropatía diabética años antes de la aparición de...